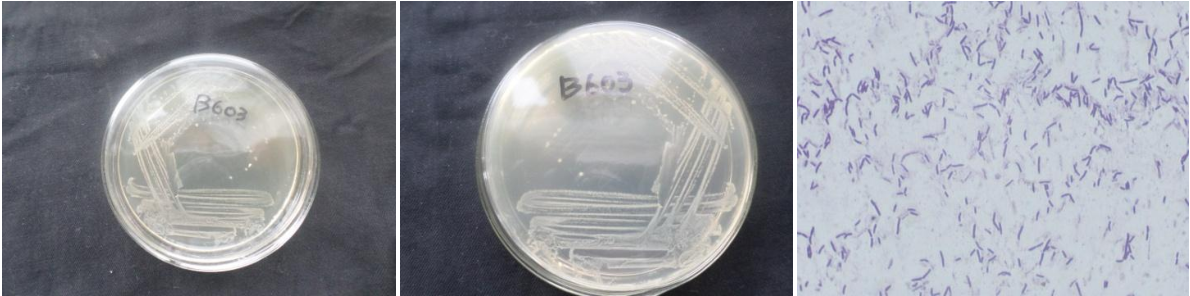

Loading...
| StrainNO | B603 |
| Classification | Halobacillus |
| 16s rDNA sequence | TTGCAGTGCGGGTGCTATACATGCAGTCGAGCGCGGGAAGCGAGTGGATCCCTTCGGGGTGAAGCTCGTGGAACGAGCGGCGGACGGGTGAGTAACACGTGGGCAACCTGCCTGTAAGACCGGAATAACCCCGGGAAACCGGGGCTAATGCCGGGTAATACTTTTCTTCGCATGAAGGAAAGTTGAAAGATGGCTTCTTGCTATCACTTACAGATGGGCCCGCGGCGCATTAGCTAGTTGGTGAGGTAACGGCTCACCAAGGCGACGATGCGTAGCCGACCTGAGAGGGTGATCGGCCACACTGGGACTGAGACACGGCCCAGACTCCTACGGGAGGCAGCAGTAGGGAATCTTCCGCAATGGACGAAAGTCTGACGGAGCAACGCCGCGTGAACGATGAAGGTCTTCGGATCGTAAAGTTCTGTTGTTAGGGAAGAACAAGTACCGTGCGAATAGAGCGGTACCTTGACGGTACCTAACGAGGAAGCCCCGGCTAACTACGTGCCAGCAGCCGCGGTAATACGTAGGGGGCAAGCGTTGTCCGGAATTATTGGGCGTAAAGCGCGCGCAGGCGGTTCCTTAAGTCTGATGTGAAAGCCCACGGCTCAACCGTGGAGGGTCATTGGAAACTGGGGAACTTGAGGACAGAAGAGGAGAGTGGAATTCCACGTGTAGCGGTGAAATGCGTAGATATGTGGAGGAACACCAGTGGCGAAGGCGACTCTCTGGTCTGTTTCTGACGCTGAGGTGCGAAAGCGTGGGTAGCAAACAGGATTAGATACCCTGGTAGTCCACGCCGTAAACGATGAGTGCTAGGTGTTAGGGGGCTTCCACCCCTTAGTGCTGAAGTTAACGCATTAAGCACTCCGCCTGGGGAGTACGGCCGCAAGGCTGAAACTCAAAGGAATTGACGGGGGCCGCACAAGCGGTGGAGCATGTGGTTTAATTCGAAGCAACGCGAAGACCTTTACCAGGTCTTGACATCTTGGACATCCTAGAAAATAGGCTTTCCCTTCGGGACCAGTGACAGGTGTGCATGATGTCGTCAGCTCGTTCGTGAGAATGTTGGGCTAGTCCCGCACGAGCGCACCCTAAATCTTTAGTTTGCCAGCATCAGTTGGCACTCTTAGGGTACTGCGTGAACAACGGAAGAGCGATGACTCATCTCTATGCCGTATGTGACCTGGGGTATACACAGAA TGGC |
| Strain Morphology Photos | |
| Morphological Description | Colony round;clam white;edge neatly;steamed bun shaped;Slightly convex in the middle;Fine wrinkle;slippy;sticky:Rod;having spore;Mesophilic budding spore |